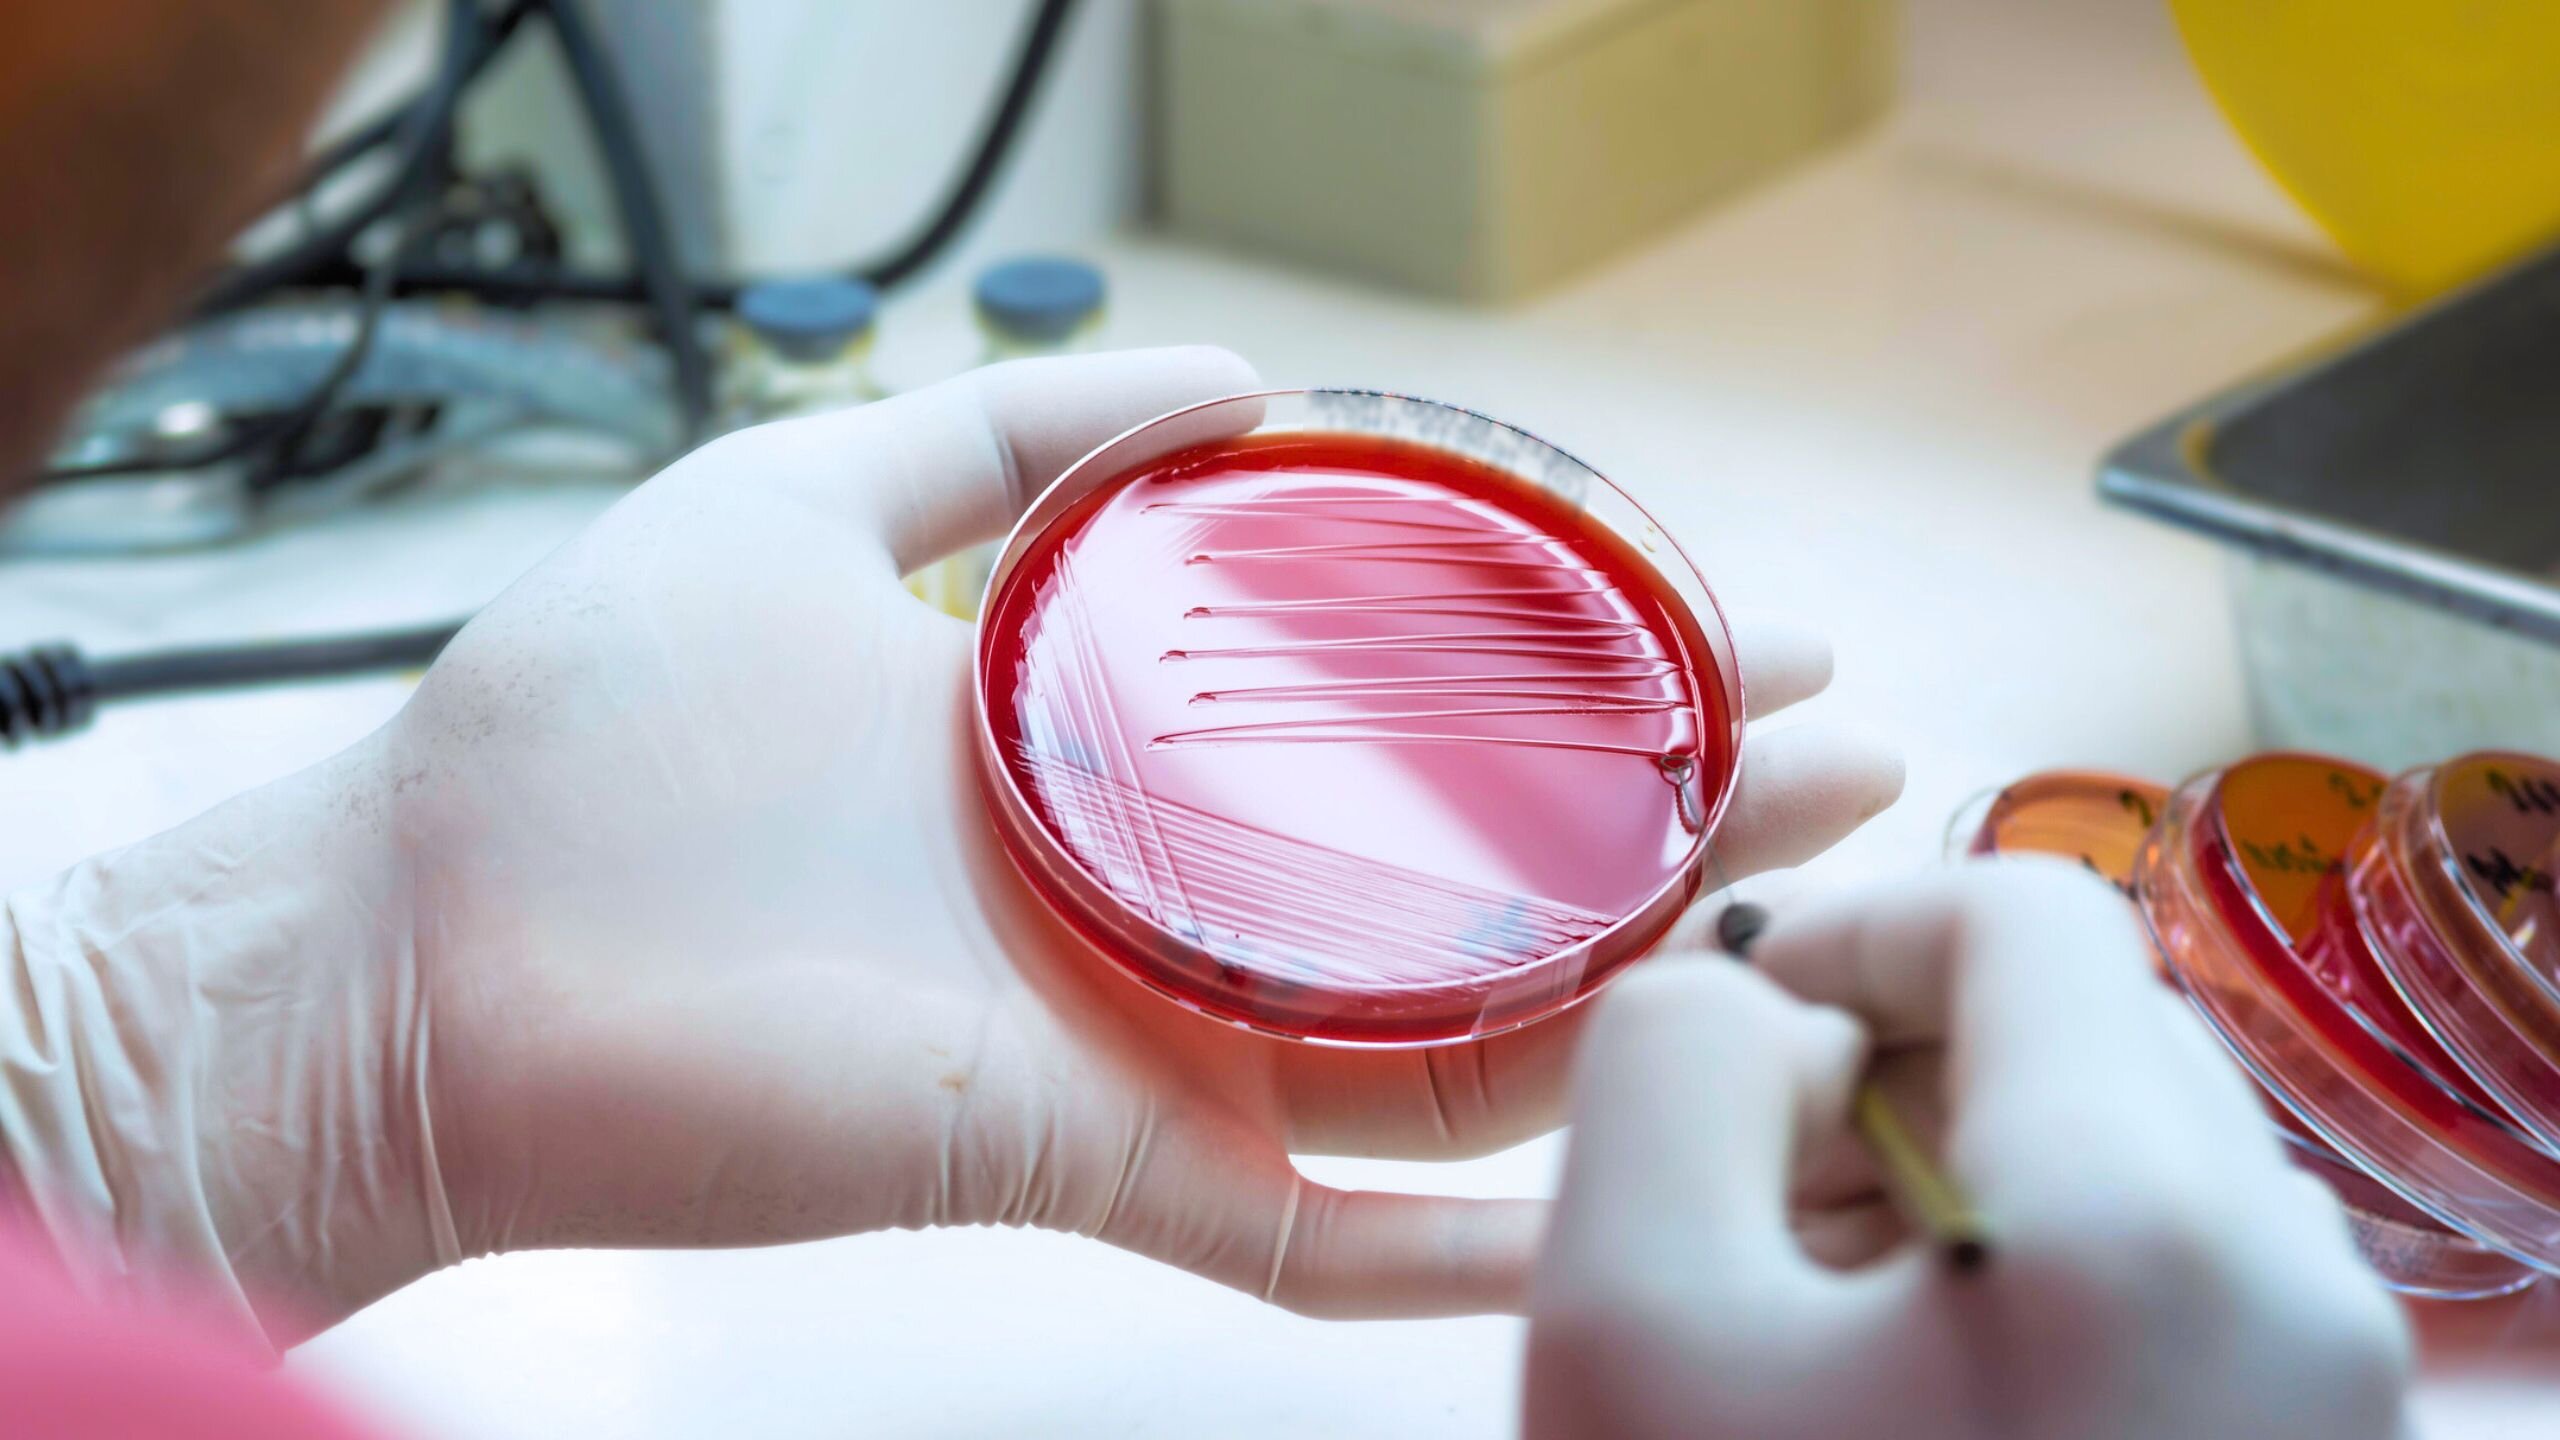
Une bactérie streptococcique peu connue à l'origine du nombre croissant d'infections graves en Australie

Selon une nouvelle étude publiée dans Le microbe Lancet.
L’étude, dirigée par l’Institut Peter Doherty pour les infections et l’immunité (Doherty Institute), a examiné les infections invasives causées par Streptococcus dysgalactiae sous-espèce equisimilis (SDSE), un proche cousin de Streptococcus pyogenes (streptocoque du groupe A ou Strep A). Comme le streptocoque du groupe A, le SDSE peut provoquer des infections de la peau et des tissus mous et, dans les cas graves, envahir le sang et les organes, entraînant une maladie potentiellement mortelle.
Pour la première fois, des chercheurs ont mesuré le fardeau des infections invasives au SDSE à travers l’Australie, en comparant les tendances dans le sud-est de l’Australie et dans le Top End du Territoire du Nord. L’équipe a analysé plus d’une décennie de données cliniques et génomiques provenant d’hôpitaux à travers les régions.
S’appuyant sur des recherches antérieures sur le streptocoque du groupe A, ils ont comparé l’incidence, les données démographiques et les résultats des infections invasives au SDSE (iSDSE) avec ceux du streptocoque invasif du groupe A (iGAS), découvrant des différences importantes dans la façon dont les deux agents pathogènes se propagent et qui ils affectent.
Le Dr Ouli Xie de l’Université de Melbourne, chercheur clinicien au laboratoire Davies-Tong de l’Institut Doherty et premier auteur de l’article, a déclaré que l’étude a révélé une augmentation des taux d’infection et des disparités entre les régions.
« Nous avons constaté que, dans les zones urbaines du sud-est de l’Australie, les infections à l’iSDSE se sont produites à un rythme similaire à celui de l’iGAS et ont augmenté régulièrement entre 2011 et début 2023. Dans les régions éloignées du nord, l’iSDSE était moins fréquent que l’iGAS, mais le nombre de cas était toujours 25 % plus élevé qu’en Australie du sud-est », a déclaré le Dr Xie.
« Pendant des années, le SDSE a été considéré comme un acteur mineur par rapport au streptocoque du groupe A, mais notre étude montre qu’il est à l’origine d’un fardeau important et croissant de maladies graves en Australie, principalement chez les Australiens plus âgés. »
Le professeur agrégé Mark Davies de l’Université de Melbourne, chef de laboratoire au Doherty Institute et co-auteur principal, a déclaré que l’analyse génomique d’échantillons de patients a révélé des informations importantes.
« Le séquençage du génome a révélé que, bien que le SDSE et le streptocoque du groupe A soient étroitement liés, ils se comportent différemment en termes de transmission et de récidive, et affectent les populations différemment », a déclaré le professeur agrégé Davies.
« Cela suggère que les stratégies de contrôle utilisées pour l’iGAS, comme l’administration d’antibiotiques aux contacts étroits, pourraient ne pas fonctionner aussi bien pour l’iSDSE. »
L’équipe a également découvert que plus d’un cas sur quatre était lié au stG62647, un clone bactérien du SDSE qui se propage rapidement en Europe et en Amérique du Nord, et maintenant en Australie.
Le professeur Steven Tong du Royal Melbourne Hospital, chef de groupe et chercheur clinicien au Doherty Institute et co-auteur principal, a déclaré que les résultats mettent en lumière les inégalités en matière de santé auxquelles sont confrontés les Australiens des Premières Nations dans les régions éloignées.
« Dans le Top End lui-même, qui présentait déjà des taux d’iSDSE plus élevés que le sud-est de l’Australie, les Australiens des Premières Nations ont été touchés de manière disproportionnée, connaissant plus de trois fois le risque de maladie invasive par rapport aux individus non membres des Premières Nations », a déclaré le professeur Tong.
« Nous avons besoin de toute urgence de stratégies qui s’attaquent aux déterminants sociaux de la santé à l’origine de ce fardeau, ainsi que de nouvelles approches pour prévenir et traiter les infections invasives à streptocoques. »
Avec les recherches iGAS antérieures de l’équipe, les résultats fournissent l’image la plus complète à ce jour de la maladie streptococcique invasive en Australie.
Ils soulignent le besoin urgent d’une surveillance améliorée, d’une prévention dans les communautés vulnérables et d’une exploration de vaccins ou de produits thérapeutiques, des partenaires industriels tels que Moderna exprimant déjà leur intérêt pour les données génomiques dans le but de développer un vaccin qui pourrait fonctionner à la fois contre le SDSE et le streptocoque du groupe A.
Fourni par l’Institut Peter Doherty pour les infections et l’immunité